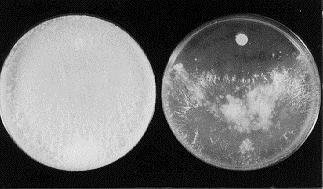

We have developed a simple system for determining if strains of N. crassa produce functional CuZn superoxide dismutase. We previously isolated N. crassa mutants with null alleles of the sod-1 gene, which encodes this enzyme (Chary et al. submitted). In initial analyses with sod-1 mutants, we used the time-consuming method of preparing protein extracts, followed by acrylamide gel electrophoresis, to identify mutant strains. We discovered that the mutant allele can be scored by inoculating the strain in question onto a plate of Vogel's N medium opposite a sterile filter-paper disk dipped in a 100-500 mM solution of the superoxide-generating compound paraquat. Wild-type strains quickly overgrow the paraquat disk, while sod-1 mutants are visibly inhibited (Fig. 1). We score strains after 2-4 days. It should be noted that strains null for sod-1 typically exhibit a zone of slimelike growth near the inhibition front; this should not be mistaken for bacterial contamination.
The method is particularly useful for scoring progeny from crosses in which one parent is null for sod-1. It is even possible to distinguish the sod-1 null allele from puu-1, which itself confers sensitivity to paraquat (Davis et al. 1991 Arch. Biochem. Biophys. 285:297-305), since puu-1 strains are substantially less sensitive than sod-1 strains when the assay is performed on standard media.
We have now used this method to transfer the sod-1 allele into several different genetic backgrounds including a mating type, which required recombination between sod-1 and the closely-linked mating-type locus. The following four strains carrying the null allele 3C of sod-1 (Chary et al. submitted) have been deposited with FGSC: DN101 (sod-1 A), DN102 (sod-1 a), DN103 (fl sod-1 A) and DN104 (fl sod-1 a). The screening method reported here should prove useful to investigators employing these strains.
Fig. 1. Assay method. Wild type (left) and sod-1 (right) strains were inoculated onto Vogel's N medium
opposite a Whatman #1 filter-paper disk that had been dipped in 500 mM paraquat. The plates were
photographed after several days growth at room temperature.